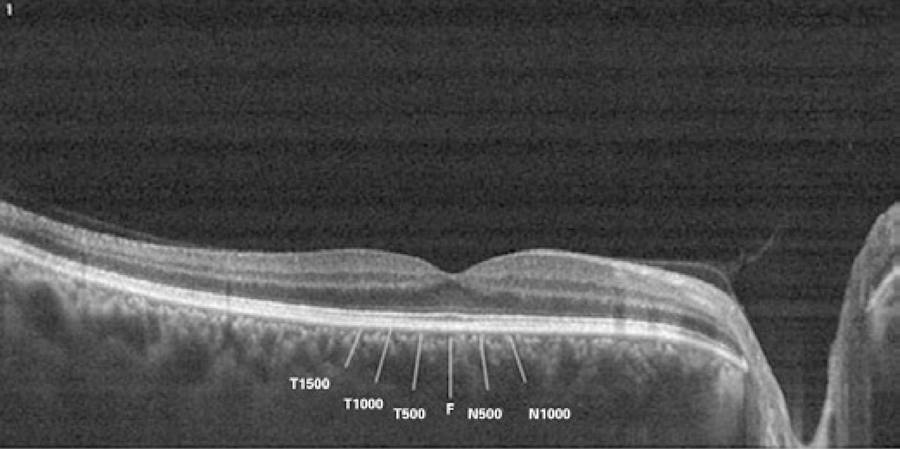

INTRODUCTION
Hemodialysis is the diffusion of molecules in solution across a semipermeable membrane through an electrochemical concentration gradient. The main objective of hemodialysis is to repair the intracellular and extracellular fluid environment. This is accomplished by the transport of solutes such as urea from the blood into the dialysate and by the transport of solutes such as bicarbonate from the dialysate into the blood(1,2). Hemodialysis is required for the survival of patients with renal failure and end-stage renal disease (ESRD) by filtering the blood, it corrects the excessive accumulation and abnormal distribution of solutes in body fluids(3). Thus, changes in the systemic hemodynamic and metabolic parameters associated with hemodialysis may affect ocular fluid dynamics and composition, blood vessels, tissues of the retina, the choroid, and the optic nerve(4-6).
The choroid provides oxygen and nutrients to the outer layers of the retina as well as the visible pigmentation of the fundus. The choroidal vessels can expand and contract easily, so that changes in intraocular or extraocular vascular pressure can affect the choroidal thickness(7). Because the choroid plays an important role in the pathophysiology of many retinal diseases, it is important to understand the anatomic structure and functional status of the choroid(8). Optical coherence tomography (OCT) is a noninvasive, interferometric optical imaging technique that provides high-resolution cross-sectional images of the retina using the reflectivity of light waves(9,10).
Evaluation of the choroid using spectral-domain optical coherence tomography (SD-OCT) was recently reported to be valuable because choroidal change has been associated with the pathogenesis of ocular diseases, such as central serous chorioretinopathy, age-related macular degeneration, diabetic retinopathy, as well as in eyes with tilted optic discs, the healthy pediatric population, and pregnant women(11-16).
A recent study showed a significant increase in choroidal thickness after hemodialysis, whereas several other studies have shown a significant decrease in choroidal thickness after hemodialysis(17-20).
In this study, we investigated the changes in retinal and choroidal thicknesses before and after high-ultrafiltration-volume hemodialysis in patients with ESRD.
METHODS
Study design
Twenty-five non-diabetic ESRD patients (17 male, 8 female) undergoing hemodialysis in the Hemodialysis Unit of the Baskent University Faculty of Medicine were enrolled in this prospective study. The study was approved by the ethics committee of the Baskent University Faculty of Medicine. The research adhered to the tenets of the Declaration of Helsinki, and a detailed written informed consent form was obtained prior to each individual's participation in the study. The inclusion criteria were a best corrected visual acuity exceeding 20/200; no history of chronic ocular diseases, such as glaucoma, uveitis, age-related macular degeneration, retinal artery/vein occlusion, or diabetic retinopathy; no family history of glaucoma; and the presence of non-diabetic ESRD treated by hemodialysis with an ultrafiltration volume >2000 mL because of high interdialytic weight gain. The exclusion criteria were the presence of an ocular disease that prevented the examination of the cornea, lens, and retina; an ocular surgery and/or laser treatments and/or intravitreal injection of the eye; spherical equivalent refractive errors more than ± 3.0 diopters; and axial length between 22 mm and 24 mm. The subjects underwent a 3- to 4-h hemodialysis session three times weekly using a high-performance dialyzer at a blood flow rate of 250-300 mL/min and a standardized dialysate flow rate of 500 mL/min. A bicarbonate-containing dialysis solution was used during the hemodialysis. The causes of ESRD in the twenty-five patients included polycystic kidney disease (n=3), chronic glomerulonephritis (n=3), hypertensive nephropathy (n=13), renal amyloidosis due to familial Mediterranean fever (n=2), renal excision due to renal cancer (n=2), and chronic renal failure of unknown etiology (n=2).
All patients underwent a detailed ophthalmic examination that included visual acuity testing; refraction assessments using an auto refractometer; biomicroscopy; intraocular pressure measurement with Goldman applanation tonometry; fundus examination; and choroidal and retinal thickness measurements using OCT just before and after their hemodialysis sessions. One eye per patient was randomly selected for OCT measurement. Randomization was done using a random number generator. To obtain clear images and minimize the effect of axial length on choroidal thickness, measurements with a refractive error higher than 1 diopter were excluded from the study(21).
Measurement of retinal/choroidal thickness
Choroidal thickness measurements were performed by the same experienced technician just before and immediately after hemodialysis using a high-speed, high-resolution SD-OCT device (λ=840 nm; 26,000 A-scans/s; 5 µm axial resolution). The results were analyzed using Optovue RTVue software version 3.5 (Optovue Inc., Fremont, CA). The retinal image was obtained after the patient was correctly positioned; the OCT device was pushed toward the eye while the patient maintained fixation. The scan pattern followed the retinal cross line, which consisted of two orthogonally oriented 6 mm lines that contained 1024 A-scans. By automatically inverting the image, the chorioretinal interface became adjacent to the zero delay. The retinal cross-line scan had an average of 32 frames, 16 per direction, without tracking(22). All basal OCT scans were performed at the same time of the day to minimize diurnal fluctuations(23). Choroidal thickness was measured perpendicularly from the outer edge of the retinal pigment epithelium to the choroid-sclera boundary at the fovea and at five more points located at the fovea; 500 µm and 1000 µm nasal to the fovea and 500 µm, 1000 µm, and 1500 µm temporal to the fovea (Figure 1). Choroidal thickness measurements were performed by two masked physicians (AK and CK). The average of the three measurements was taken; the differences between readings of the masked physicians were found to be within 10 µm of the mean. The interexaminer reproducibility of the choroidal thickness measurements was assessed by measuring the intraclass correlation coefficient (ICC).
Figure 1 T-1500, choroidal thickness at 1500 µm temporal to the fovea; T-1000, choroidal thickness at 1000 µm temporal to the fovea; T-500, choroidal thickness at 500 µm temporal to the fovea; F, choroidal thickness at the fovea; N-500, choroidal thickness at 500 µm nasal to the fovea; N-1000, choroidal thickness at 1000 µm nasal to the fovea; N-1500, choroidal thickness at 1500 µm nasal to the fovea.
Statistical analysis
Statistical analyses were performed using the Statistical Package for the Social Sciences (SPSS) version 11.0 (SPSS Inc, Chicago, IL, USA). The Wilcoxon test was used to compare the systemic hemodynamic and ocular variables before and after hemodialysis in each group. Differences between the groups were analyzed using the Mann-Whitney U test. The intraclass correlation coefficient (ICC) was calculated to quantify the reproducibility of manual re-measurements of the choroidal and retinal thicknesses in cases of alignment errors. The ocular perfusion pressure (OPP) was calculated using the following formula: OPP=2/3 × (mean arterial pressure - intraocular pressure). The mean arterial pressure (MAP) was calculated using the following formula: MAP=diastolic arterial pressure - 1/3 × (systolic arterial pressure - diastolic arterial pressure). Differences resulting in P values of <0.05 were considered statistically significant.
RESULTS
General patient information is presented in table 1. The median choroidal thickness at the fovea decreased significantly during hemodialysis; changing from 182 µm (range, 103-374 µm) to 161 µm (range, 90-353 µm) (P<0.001). Moreover, significant differences in median choroidal thicknesses were found before and after hemodialysis at all points where measurements were taken (P<0.001 for all) (Figure 2). However, hemodialysis did not cause a significant decrease in median retinal thickness (246 µm [range, 179-296 µm] before versus 248 µm [range, 141-299 µm] after hemodialysis; [P=0.12]). The interexaminer ICCs for the choroidal and retinal thicknesses were 0.918 (95% confidence interval [CI], 0.908-0.982) and 0.922 (95% CI, 0.906-0.979), respectively. The ICC was greater than 0.90 for measurements taken at all points. Figure 3 shows a comparison of the median choroidal and retinal thicknesses measured by two different observers before and after hemodialysis. Systolic arterial pressures (SAPs), diastolic arterial pressures (DAPs), MAPs, ıntraocular pressures (IOPs), heart rates, and OPPs before and after hemodialysis are presented table 2. Decreases in heart rate, SAP, DAP, MAP, and OPP were statistically significantly (P<0.001), but the change in IOP was not statistically significant (P=0.540).

Figure 3 Comparison of choroidal measurements taken before and after hemodialysis by two different observers.
Table 1 General patient information
| Age | Mean ± Sd | range |
|---|---|---|
| Sex | 44.6 ± 12.7 | 20-60 |
| Male | 17.0 (68%) | |
| Female | 8.0 (32%) | |
| HD duration (months) | 42.8 | 8.0-76.0 |
| Ultrafiltration volume (mL) | 3136.0 ± 578.0 | 2000-4500 |
HD= hemodialysis; SD= standard deviation.
Table 2 Effect of hemodialysis on systemic and ocular parameters
| Before hd | After hd | ||
|---|---|---|---|
| mean ± Sd | mean ± Sd | P value | |
| IOP (mmHg) | 16.8 ± 3.0 | 16.7 ± 3.6 | 0.540 |
| Heart rate (beats/min) | 77.2 ± 5.4 | 74.2 ± 5.1 | <0.001 |
| Blood pressure (mmHg) | |||
| Systolic | 131.6 ± 13.1 | 119.0 ± 10.7 | <0.001 |
| Diastolic | 82.6 ± 11.1 | 70.8 ± 9.3 | <0.001 |
| Mean | 98.6 ± 10.6 | 87.2 ± 9.1 | <0.001 |
| Ocular perfusion pressure | 48.9 ± 8.5 | 41.4 ± 7.3 | <0.001 |
HD= hemodialysis; mmHg= millimeters of mercury; SD= standard deviation.
DISCUSSION
In this current study, choroidal thickness measurements taken at six different points decreased significantly during hemodialysis, but foveal retinal thickness did not change. These findings could be the result of choroidal changes associated with hypertension and fluid retention in renal failure patients. Decreased plasma colloidal osmotic pressure due to decreased serum protein levels and increased hydrostatic pressure associated with hypertension may also alter the hemodynamics in the retinal capillaries. Prior to hemodialysis, fluid retention causes a decrease in plasma colloidal osmotic pressure due to the increased plasma volume. Because this decrease produces a colloidal osmotic gradient between the plasma and interstitial volume, water passes from the interstitial fluid into the plasma(24). Changes in MAP affect the blood velocity and retinal blood flow positively, and hemodialysis leads to changes in systemic circulatory parameters such as hematocrit, systemic blood pressure (SBP), and the amount of fluid circulation in ESRD patients. The main mechanism driving diminished retinal blood flow during hemodialysis is hypothesized to be related to the amount of fluid removed during hemodialysis. Retinal blood flow and the amount of fluid removed by hemodialysis were found to be negatively correlated(6). Because the aim of hemodialysis is to correct the abnormal distribution of bodily fluids, ocular hemodynamics are expected to be affected by this rearrangement. In one study, researchers reported several hemodialysis-related changes, including decreased visual acuity, IOP, corneal thickness, and basal tear secretion; however, the authors found no significant change in retinal thickness using SD-OCT(4). The authors concluded that the shifting of water from the interstitial fluid into the plasma results in a drop in tear secretion, aqueous production, and corneal hydration. In another study, researchers reported that the IOP, OPP, and SAP did not vary significantly in ESRD patients during hemodialysis(25). We also did not observe a significant change in IOP; however, OPP, SAP, DAP, and MAP decreased significantly. In another study, researchers found decreases in both the systolic and diastolic blood flow velocities of the ophthalmic artery, central retinal artery, central retinal vein, and nasal and temporal posterior ciliary arteries of both eyes after hemodialysis(26). Their study was conducted using color Doppler imaging. We consider that a loss of interstitial fluid and a decrease in ocular blood flow were the two underlying causes of the significant decrease in choroidal thickness detected in this current study.
In a recent study, researchers reported that choroidal thickness increased and SBP decreased after a hemodialysis session(17). They proposed that the increase in choroidal thickness may be associated with choroidal autoregulatory control of ocular hemodynamics; a shifting of fluid and molecules between the plasma and choroidal interstitium. On the other hand, other researchers have reported a significant decrease in choroidal thickness after hemodialysis(18-20). They assert that ultrafiltration-dependent hypovolemia, the removal of intravascular and interstitial fluid due to raised plasma colloid osmotic pressure(18,19), and a reduction in the area of the choroidal vasculature(20) may cause the decrease in choroidal thickness. Our results are similar to the results of these studies. In one of these studies, it was reported that the decrease in choroidal thickness following hemodialysis was higher in patients with diabetes than in patients without diabetes. The authors stated that this decrease was due to a damage to the choroidal vessels in patients with diabetes(19).
With the availability of SD-OCT devices, high-resolution images are now available. This gives the clinician enough information to evaluate the choroid more accurately(8,27). As a highly vascular ocular structure, the choroid is directly influenced by the IOP and OPP(27); therefore, real-time, high-definition images of the choroid could help us demonstrate the real-time vascular status of this tissue in vivo. A group of researchers found an age-correlated decrease in retinal thickness in all quadrants in hemodialysis patients compared with healthy controls(28).
There were some limitations to our study. Serum osmolarity, plasma colloid serum osmotic pressure, and anterior segment parameters were not measured. These parameters could also be correlated with choroidal thickness changes.
In conclusion, we found no retinal thickness changes and significant choroidal thickness changes following hemodialysis in patients with ESRD. Because the choroid has little autoregulation, blood flow can be affected by changes in the perfusion pressure and choroidal thickness can be changed as a result of these effects. Further randomized trials with larger patient groups and additional systemic parameters could shed more light on this issue.

English PDF
Print
Send this article by email
How to cite this article
Submit a comment
Mendeley
Scielo
Pocket
Share on Linkedin

